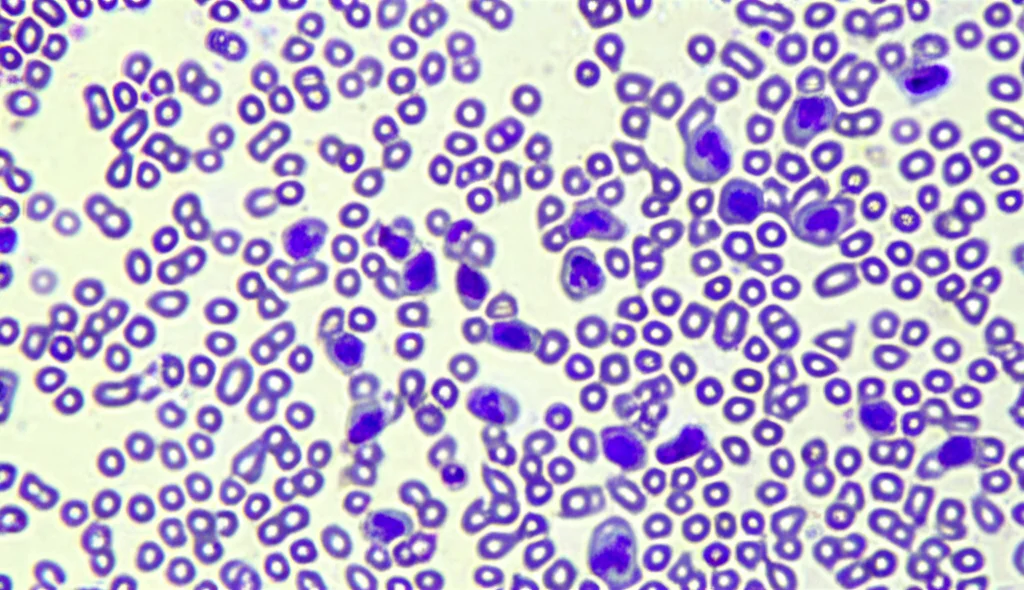
Immagine macro ad alta definizione di cellule di Leucemia Mieloide Acuta (LMA) in coltura, osservate al microscopio. Obiettivo macro 100mm, illuminazione controllata, focus preciso su alcune cellule che mostrano morfologia alterata indicativa di resistenza ai farmaci.

LMA Resistente: Svelati i Segreti Nascosti dietro il Fallimento della Chemioterapia
Ciao a tutti! Oggi voglio portarvi con me in un viaggio affascinante nel cuore di una delle sfide più grandi dell’oncologia moderna: la Leucemia Mieloide Acuta (LMA), in particolare quando diventa refrattaria o recidivante (R/R). Immaginate un nemico aggressivo, un tumore del sangue che colpisce duro. Per decenni, abbiamo combattuto questa battaglia con armi potenti come la citarabina (Ara-C) e la daunorubicina (DNR), spesso usate insieme nel famoso regime “7+3”. Questi farmaci sono stati la nostra prima linea di difesa, e per molti pazienti funzionano. Ma cosa succede quando il nemico impara a resistere?
Il Nemico Invisibile: La Resistenza alla Chemioterapia nella LMA
Purtroppo, una percentuale significativa di pazienti, specialmente quelli più anziani o quelli con specifiche caratteristiche genetiche come l’assenza di mutazioni nel gene FLT3 (wild-type), non risponde più alle terapie standard o ha una ricaduta dopo un periodo di remissione. Questa è la LMA R/R, un vero rompicapo clinico. Mentre per i pazienti con mutazioni FLT3-ITD esistono terapie mirate, per quelli con FLT3 wild-type le opzioni si riducono drasticamente, e spesso si ritorna proprio a quei farmaci, Ara-C e DNR, che hanno già fallito una volta. Come potete immaginare, i tassi di successo in seconda linea sono bassi, circa il 40-50% dei pazienti non raggiunge la remissione completa. È chiaro che dobbiamo capire perché queste cellule tumorali diventano così resistenti. Non basta classificare il rischio o prevedere la risposta; dobbiamo svelare i meccanismi biologici alla base del fallimento. Ed è proprio quello che abbiamo cercato di fare.
Sotto la Lente: Come Abbiamo Studiato la Resistenza
Per capire cosa succede a livello molecolare, abbiamo preso una linea cellulare di LMA con FLT3 wild-type, chiamata SHI-1, e l’abbiamo “allenata” a resistere all’Ara-C. Come? Sottoponendola a lungo termine a dosi crescenti del farmaco. Il risultato è stata una nuova linea cellulare, che abbiamo chiamato RHI-1, super resistente all’Ara-C. Abbiamo poi messo alla prova entrambe le linee cellulari, SHI-1 (le “sensibili”) e RHI-1 (le “resistenti”), non solo con Ara-C ma anche con DNR, sia da soli che in combinazione. Come previsto, le cellule RHI-1 se la ridevano dell’Ara-C. Ma la sorpresa è stata scoprire che erano diventate significativamente più tolleranti anche alla DNR, un farmaco con un meccanismo d’azione diverso! Sembrava quasi che la resistenza all’Ara-C avesse conferito una sorta di “superpotere” generale contro la chemio. Ci siamo chiesti: forse le cellule resistenti semplicemente non fanno entrare i farmaci? Abbiamo misurato le concentrazioni di Ara-C e DNR all’interno delle cellule SHI-1 e RHI-1. E qui, altra sorpresa: le cellule RHI-1 resistenti accumulavano più DNR al loro interno rispetto alle cellule sensibili SHI-1, e anche l’assorbimento di Ara-C in combinazione con DNR era maggiore nelle RHI-1! Eppure, nonostante avessero più “veleno” dentro, sopravvivevano meglio. Questo ci ha detto una cosa fondamentale: la resistenza non era (solo) una questione di “porte chiuse”, ma doveva esserci qualcosa di più profondo, un meccanismo che permetteva alle cellule RHI-1 di neutralizzare l’effetto tossico dei farmaci una volta entrati.
Decifrare il Codice: Proteomica e Fosfoproteomica Rivela i Segreti
Per scavare più a fondo, abbiamo usato tecniche potentissime chiamate proteomica e fosfoproteomica. Immaginate di poter fare una fotografia istantanea di tutte le proteine presenti in una cellula (proteomica) e di vedere quali di queste sono “accese” o “spente” tramite una modifica chimica chiamata fosforilazione (fosfoproteomica). Questo ci dà un quadro incredibilmente dettagliato di cosa sta succedendo a livello molecolare. Confrontando le cellule RHI-1 (resistenti, trattate e non) con le SHI-1 (sensibili, non trattate), abbiamo mappato migliaia di proteine e siti di fosforilazione. Analizzando le differenze, sono emersi dei pattern chiarissimi. Le cellule RHI-1 resistenti, soprattutto quando esposte ai farmaci, mostravano un aumento significativo di proteine coinvolte in tre processi chiave:
- Metabolismo mitocondriale: Un vero e proprio cambio di marcia energetico.
- Riparazione del DNA: Sistemi super efficienti per correggere i danni indotti dalla chemio.
- Detossificazione da Specie Reattive dell’Ossigeno (ROS): Meccanismi potenziati per neutralizzare molecole dannose prodotte dai farmaci.
Abbiamo costruito un modello, una sorta di mappa concettuale, per visualizzare come questi percorsi interagissero tra loro. Era come aver trovato la “centrale operativa” della resistenza!
Il Cuore Energetico della Resistenza: Il Metabolismo Mitocondriale
Una delle scoperte più intriganti è stata proprio questa virata verso il metabolismo mitocondriale. Normalmente, molte cellule tumorali preferiscono la glicolisi (un modo più “veloce” ma meno efficiente di produrre energia, anche in presenza di ossigeno – il famoso effetto Warburg). Le nostre cellule RHI-1 resistenti, invece, facevano il contrario: riducevano la glicolisi e potenziavano la respirazione mitocondriale (OXPHOS). Perché? I mitocondri non sono solo le “centrali energetiche” della cellula (producono molto più ATP, la nostra moneta energetica), ma forniscono anche i mattoni fondamentali per costruire nuove molecole, inclusi i nucleotidi necessari per riparare il DNA danneggiato dalla chemio. Inoltre, un enzima chiave per l’attivazione dell’Ara-C (DCK) era meno espresso nelle cellule resistenti, spingendole a produrre i propri nucleotidi da zero (sintesi de novo), un processo che si appoggia proprio sul buon funzionamento dei mitocondri. Insomma, potenziando i mitocondri, le cellule RHI-1 si assicuravano energia e materiali per resistere all’attacco. Una proteina chiamata SIRT6 sembrava giocare un ruolo importante in questo switch metabolico e anche nella riparazione del DNA.

Scudi e Riparazioni: Il Ruolo della Riparazione del DNA e della Detossificazione
La chemioterapia, in particolare la DNR, agisce danneggiando il DNA delle cellule tumorali. Se il danno è troppo esteso, la cellula muore. Ma le nostre cellule RHI-1 avevano affinato i loro sistemi di riparazione del DNA. Proteine come ATM, RAD50/51/54, XPC, SIRT6, e DNA-PKcs (che abbiamo visto essere più attiva nelle cellule resistenti) erano pronte a intervenire rapidamente per correggere le lesioni, permettendo alla cellula di sopravvivere. Inoltre, la DNR genera anche stress ossidativo producendo molecole reattive (ROS) che possono danneggiare ulteriormente la cellula e i suoi mitocondri. Le cellule RHI-1 rispondevano potenziando le loro difese antiossidanti, con proteine come CAT (catalasi), GPX7 e FTH1 che neutralizzavano i ROS. Questo non solo proteggeva la cellula, ma evitava anche un tipo di morte cellulare indotta dal ferro chiamata ferroptosi e manteneva i mitocondri funzionanti. Abbiamo confermato l’aumento di SIRT6, della forma attiva di DNA-PKcs e di CAT nelle cellule RHI-1 trattate tramite analisi specifiche (immunoblotting). È affascinante vedere come queste cellule mettano in campo una strategia difensiva su più fronti! E la cosa ancora più interessante è che analizzando dati pubblici da campioni di pazienti reali con LMA R/R (sia adulti che pediatrici, con FLT3 wild-type), abbiamo ritrovato arricchimenti simili in questi stessi percorsi: metabolismo mitocondriale, riparazione del DNA e detossificazione dai ROS. Questo suggerisce che i meccanismi scoperti nelle nostre cellule RHI-1 potrebbero essere davvero rilevanti nella clinica.
Mettere alla Prova le Scoperte: Inibitori e Cellule Pazienti
Se la nostra ipotesi era corretta, colpire questi meccanismi di difesa avrebbe dovuto rendere le cellule RHI-1 di nuovo vulnerabili alla chemioterapia. E così abbiamo fatto. Abbiamo usato degli inibitori specifici:
- Un inibitore di SIRT6: Ha ridotto la sopravvivenza delle cellule RHI-1 trattate con DNR e Ara-C, confermando il ruolo di SIRT6 nella resistenza (probabilmente agendo sia sul metabolismo che sulla riparazione del DNA).
- Un inibitore di GPD2 (un enzima a monte del complesso III dell’OXPHOS): Ha avuto un certo effetto, ma non clamoroso.
- Il Rotenone, un noto inibitore del complesso I dell’OXPHOS (il primo passo della catena respiratoria mitocondriale): Questo è stato il colpo da maestro! Il Rotenone ha drasticamente ridotto la vitalità delle cellule RHI-1 trattate con Ara-C e DNR, riportandola quasi ai livelli delle cellule sensibili SHI-1. Bloccare il complesso I sembrava mandare in tilt l’intera strategia di sopravvivenza basata sui mitocondri.
Ma la prova del nove doveva venire dai pazienti. Abbiamo preso campioni di cellule da pazienti con LMA che rispondevano alla terapia e da pazienti con LMA R/R. Come previsto, le cellule R/R erano meno sensibili ad Ara-C e DNR. Ma quando abbiamo aggiunto l’inibitore di SIRT6 o il Rotenone, le cellule R/R sono diventate significativamente più sensibili alla chemio, mentre le cellule dei pazienti responsivi non hanno mostrato grandi cambiamenti o, in alcuni casi con Rotenone, sono sembrate persino leggermente protette (forse perché inibire i mitocondri interferisce anche con un meccanismo di morte indotto dalla DNR stessa in cellule non ancora “adattate”). Questi risultati sui pazienti rafforzano l’idea che colpire il metabolismo mitocondriale (specialmente il complesso I) e la riparazione del DNA sia una strategia promettente proprio per i casi difficili di LMA R/R.

Verso Nuove Strategie Terapeutiche: Implicazioni Cliniche
Cosa ci dice tutto questo? Che la resistenza alla chemioterapia nella LMA R/R con FLT3 wild-type non è un destino ineluttabile, ma un processo biologico complesso che possiamo iniziare a decifrare e, speriamo, a contrastare. Le cellule tumorali resistenti non sono semplicemente “più forti”, ma si adattano, cambiano il loro metabolismo, potenziano le loro difese. La scoperta che il metabolismo mitocondriale, la riparazione del DNA e la detossificazione dai ROS sono così cruciali apre nuove strade terapeutiche. Non siamo i soli a pensarla così. Esistono già farmaci in clinica, come il Venetoclax (un inibitore di BCL-2, una proteina legata alla sopravvivenza cellulare e ai mitocondri), che in combinazione con altri agenti sta dando ottimi risultati proprio nella LMA, specialmente nei pazienti anziani, agendo anche sul metabolismo mitocondriale. I nostri risultati suggeriscono che inibire direttamente la funzione mitocondriale, magari proprio il complesso I dell’OXPHOS, potrebbe essere un’arma in più per potenziare l’efficacia di chemioterapici classici come Ara-C e DNR in quei pazienti che altrimenti non avrebbero molte altre speranze. Certo, la strada è ancora lunga e servono studi clinici per confermare queste ipotesi, ma aver identificato questi meccanismi è un passo fondamentale. Capire il nemico è il primo passo per sconfiggerlo. E noi siamo determinati a continuare questa battaglia, armati di nuova conoscenza, per offrire un futuro migliore ai pazienti con LMA resistente.
Fonte: Springer
